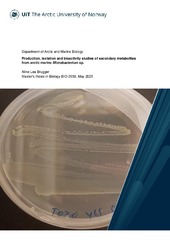
Miniatyrbilde

Institutt for arktisk og marin biologi: Nye registreringer
Viser treff 21-40 av 2086
- 
Environmental impact and efficacy of different antifouling coatings in the Atlantic and Baltic Transition marine regions 
(Master thesis, 2025)This thesis evaluates the environmental impact and efficacy of various antifouling (AF) coatings under field conditions across three marine sites in the Baltic Transition and Atlantic regions. The AF paints tested in the study included five copper-based coatings with varying copper content (6 – 32 wt% Cu2O), one alternative biocidal coating containing tralopyril and one biocide-free silicone foul ... - 
Factors predicting migration patterns in the world’s northernmost moose population in Finnmark 
(Master thesis, 2025)Abstract Purpose. The purpose of the study was to investigate factors predicting migration pattern in moose in Finnmark. Moose has earlier been most numerous in the central and southern part of Norway, but the moose population in Finnmark increased in the 1990’s, and has now reached a more stable state. This makes a study on how the moose behaves in a relatively new habitat of particular ... - 
Seasonal dynamics in RNA:DNA ratios of marine microbial communities in a high latitude estuary 
(Master thesis, 2025)Microorganisms are key players in marine ecosystems, as they form the basis of food webs and drive biogeochemical cycling. Global warming increases sea surface temperatures and the frequency of marine heatwaves, but the effect on marine microbes is still not well understood. To predict future changes of marine ecosystems, it is therefore important to understand the direct impact of increased ... - 
Development and Application of an Ex Vivo Adipose Tissue-based Model from Cetacean Blubber Biopsies to Study Impacts of Stress Hormones 
(Master thesis, 2025)Cetaceans serve as ecosystem engineers and sentinel species for ocean and human health. They are exposed to various anthropogenic stressors, including pollution, noise, human activities, and climate change which contribute to high levels of stress hormones such as glucocorticoids (e.g. cortisol). While stress response mechanisms are vital in the short term, prolonged exposure to stress can have ... - 
Survival and predation of Atlantic salmon smolts in anadromous watersheds with lakes: a case study from the Skienselva watershed 
(Master thesis, 2025)Atlantic salmon (Salmo salar) exhibit marked niche shifts between spawning and juvenile recruitment in running freshwaters and growth in marine waters. These habitat shifts necessitate long migrations which may come at a substantial cost to the population. As smolts, Atlantic salmon migrate downstream, from freshwater rivers to salty ocean environment, transitioning between two very distinct aquatic ... - 
Movements, diving behavior and group fidelity of long-finned pilot whales in Northern Norway 
(Master thesis, 2025)Long-finned pilot whales (Globicephala melas) are widely distributed and abundant throughout the North Atlantic and sightings have appeared to increase in coastal areas in northern Norway over the past decade. However, little is known about the dynamics and ecological drivers of their movements in this region. Therefore, we deployed 11 satellite-linked tags to determine areas of important habitat, ... - 
Spatio-temporal distribution of Atlantic salmon (Salmo salar) post-smolt in Sognefjord 
(Master thesis, 2025)Atlantic salmon (Salmo salar) is an anadromous fish that migrates from fresh to salt water, facing many challenges and threats throughout their life cycle, particularly during post-smolt migration through fjords. This study investigates the spatio-temporal distribution of Atlantic salmon post-smolts in Sognefjord, using data from the national monitoring program of salmon lice on wild salmonids (NALO) ... - 
Assessment of plant growth under a rapid flashing light treatment and the effectiveness of hyper- and multi-spectral imaging as phenotyping tools 
(Master thesis, 2025)Controlled environment agriculture, such as greenhouses, offers a promising solution to enhance local food production in Nordic regions, where long winters and limited natural light hinder year-round cultivation. This study investigates the effects of a rapid flashing light system on the growth and chlorophyll content of woodland strawberry Fragaria vesca, aiming to optimize energy use in greenhouse ... - 
Impacts of Pink Salmon on the Social-Ecological System: The Tana River Community Survey 
(Master thesis, 2025)Invasive alien species are major drivers of change in social-ecological systems in the world, causing changes not only in ecosystems but also affecting human systems and ecosystem services. In recent years, the Pacific pink salmon (Oncorhynchus gorbuscha) have invaded Norwegian rivers in numbers of thousands, increasing the concerns among managers regarding the impact on Norwegian ecosystems and ... - 
Overwintering Calanus finmarchicus in Ullsfjord 
(Master thesis, 2025)Calanus finmarchicus is a key species in the North Atlantic ecosystems that serves as an important link between primary producers and higher trophic levels, including commercially important fish. C. finmarchicus spends the unproductive time of the year overwintering in deep water layers. While it typically overwinters in deep oceanic basins, overwintering populations with high abundances have also ... - 
Urbanisation and Climate Shape Breeding Phenology in a Subarctic Songbird 
(Master thesis, 2025)Abstract Urbanisation alters ecological conditions in ways that can affect avian reproductive strategies, yet its impacts in high-latitude environments remain underexplored. We investigated how breeding phenology and reproductive success in pied flycatchers (Ficedula hypoleuca) vary across an urban–rural gradient in Arctic Norway, using a combination of long-term data (2007–2018) from a rural site ... - 
Whales in a bottle- using environmental DNA in combination with acoustic and visual observations to identify presence of whales in Northern Norway 
(Master thesis, 2025)Whales have several important ecological functions as top predators in marine ecosystems and may also serve as sentinels of anthropogenic activities that drive ecosystem shifts. It is therefore important to have efficient methods to monitor the spatiotemporal presence of different whale species in the vast ocean realm. Traditionally, visual observations from research vessels have been the method of ... - 
Tissue Expression of Irisin Coding Genes and the Roles in Metabolism of Rainbow Trout Cardiomyocytes 
(Master thesis, 2025)Fndc5 is the precursor to irisin, a myokine that is believed to contribute to metabolism and growth regulation. Therefore, irisin could potentially have a stimulatory effect on fish growth in aquaculture. However, the expression and physiological role of irisin in fish is largely unknown. This study aimed to increase the understanding of fndc5/irisin in Rainbow trout (Oncorhynchus mykiss) by ... - 
The Impact of artificial light on Arctic pelagic communities during the polar night How to reduce impacts by modifying color, intensity and flashing frequency 
(Master thesis, 2025)An increasing anthropogenic stressor in marine ecosystems is artificial light at night. Especially in the Arctic where exposure is increased by extended periods of darkness during the polar night. This study focuses on underwater artificial light used in occasional situations such as scientific sampling and measuring, stock assessment or lights from navigating boats. This study examines the effects ... - 
Production, isolation and bioactivity studies of secondary metabolites from arctic marine Microbacterium sp. 
(Master thesis, 2025)Bacteria have colonized countless habitats on earth, including extreme environments such as the Arctic Ocean. In 2020, a research cruise arranged by Marbio, a bioprospecting research group at UiT, went out to the Barents Sea to collect marine fungi, invertebrate, and bacteria samples. Especially Actinobacteria were of interest, as they have shown to be prolific producers of secondary metabolites. ... - 
The development of altruism in children and its parental influences 
(Master thesis, 2025)Altruistic behaviour is a type of prosocial behaviour which is costly to the actor but beneficial to the recipient. It can, in children, be influenced by numerous factors, including parental political orientation, parental religiousness, and the child's age and gender. This cross-sectional research investigates these parental influences and individual factors on altruistic behaviour of children in ... - 
Global Marine Flyways Identified for Long-Distance Migrating Seabirds From Tracking Data 
(Journal article; Tidsskriftartikkel; Peer reviewed, 2025-02-16)Aim To identify the broad-scale oceanic migration routes (‘marine flyways’) used by multiple pelagic, long-distance migratory seabirds based on a global compilation of tracking data. <p>Location Global. <p>Time Period 1989–2023. <p>Major Taxa Studied Seabirds (Families: Phaethontidae, Hydrobatidae, Diomedeidae, Procellariidae, Laridae and Stercorariidae). <p>Methods We collated a comprehensive global ... - 
A specialist predator in a food web with cyclic alternative prey:The gyrfalcon-ptarmigan case revisited 
(Journal article; Tidsskriftartikkel; Peer reviewed, 2025-05-02)<ol> <li>Population dynamics of specialist predators are tightly linked to their main prey and can in simple food webs lead to complex predator–prey interactions (e.g. predator–prey cycles). However, the strength of these interactions may be affected by the availability of alternative prey if it appears in high numbers and the predator diet is sufficiently flexible.</li> <li>A prominent example of ... - 
Roadmap to sustainably develop the European seaweed industry 
(Journal article; Tidsskriftartikkel; Peer reviewed, 2025-05-13)How to build a sustainable seaweed industry is important in Europe’s quest to produce 8 million tons of seaweed by 2030. Based on interviews with industry representatives and an expert-workshop, we developed an interdisciplinary roadmap that addresses sustainable development holistically. We argue that sustainable practices must leverage synergies with existing industries (e.g. IMTA systems, offshore ... - 
BioTIME 2.0: Expanding and Improving a Database ofBiodiversity Time Series 
(Journal article; Tidsskriftartikkel; Peer reviewed, 2025-05-14)Motivation - Here, we make available a second version of the BioTIME database, which compiles records of abundance estimates for species in sample events of ecological assemblages through time. The updated version expands version 1.0 of the database by doubling the number of studies and includes substantial additional curation to the taxonomic accuracy of the records, as well as the metadata. Moreover, ... 


English
norsk